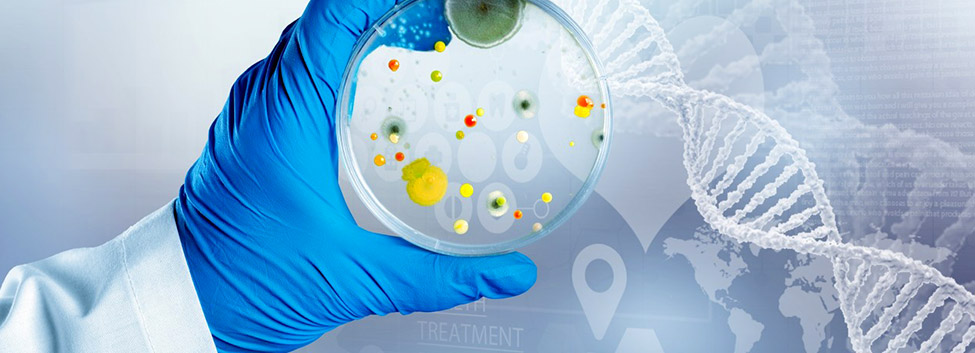

CN
ADVANCED MANUFACTYRING
先进制造技术平台
- 成分分析平台
- 失效分析平台
- 大型仪器测试平台
- 显微表征平台
- 新材料/器件检测评价平台
- 可靠性验证平台
- 新能源热管理部件及系统测试平台
- 电磁兼容(EMC)测试评价平台
成分分析平台
占位1
失效分析平台
占位1
大型仪器测试平台
占位1
显微表征平台
占位1
新材料/器件检测评价平台
占位1
可靠性验证平台
占位1
新能源热管理部件及系统测试平台
占位1
电磁兼容(EMC)测试评价平台
占位1
新闻资讯 news
时刻与您分享我们的点滴